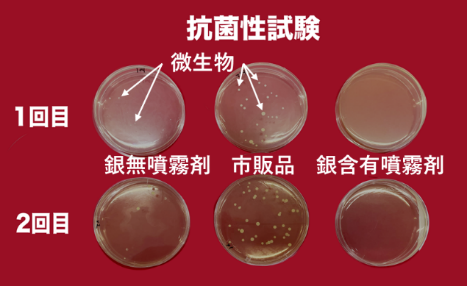

アーカイブ情報
2025/3/6
【抗菌】岐阜大学、噴霧式抗菌技術の機能向上を確認
本研究のポイント
・簡便だが感度の悪い(抗菌性が強くないと評価できない)抗菌評価法を確立
・銀イオンを用いて、抗菌・抗ウイルス性が顕著で安全性の高い噴霧式抗菌技術を開発
・銀イオンの特性である黒色化を防止する技術にようやくたどり着く
・国際標準よりも感度の悪い評価方法を用いることで、よりレベルの高い技術を開発
成果の背景
岐阜大学は、岐阜県内の企業を中心に技術的な支援活動を行っている。岐阜大学と岐阜県大垣市に本部を置く錦之堂インターナショナルと関連会社であるエイチ・アンド・ジェイは、コロナ禍の2021年11月に、噴霧式抗菌剤の社会実装試験を行う共同研究を実施した。岐阜大学では応用生物科学部故鈴木徹教授が担当し、海津市役所や、大垣共立銀行本店において評価を行った。結果は良好であり、両組織における衛生面の維持を確認するとともに、噴霧式抗菌剤がさらに公衆衛生を高めることが確認された。
その後、エイチ・アンド・ジェイと故鈴木教授の遺志を引き継いだ同学部の岩橋均教授(現名誉教授)との間で2024年3月まで噴霧式抗菌技術の機能向上を図る共同研究を行った。共同研究終了後、製品化に際しOEM企業に委託製造を依頼していたが、銀鏡反応で銀が黒色化し、取り除く工程のコストが障壁であった。岩橋名誉教授のアイデア(非開示)で、黒色化を防ぐ技術が最近になりようやく達成できた。
研究概要

抗菌性については、国際標準でISO22916(抗菌加工を施した製品の抗菌性試験方法)が定められているが、標準手法は、操作が複雑で、かつ抗菌性の効果が低い場合であっても有効と判断される。感度の高い評価方法といえる。これに対し、岩橋名誉教授は、より簡便な操作で、抗菌性が高い場合にのみ有効と判断できる感度の悪い評価手法を開発していた(上図)。例えばISO22916で有効とされる酸化チタンは、当該評価法では、抗菌性を示すことができない。
一方で、銀イオンの抗菌性は古くから知られており、安全性の高い抗菌材。しかしながら、銀イオンは環境中で光を受けると黒色化する欠点がある(銀鏡反応)。共同研究終了後、家庭や環境中で抗菌剤として利用しても黒色化しない方法を開発(非開示)し、新たな噴霧式抗菌技術を開発した。
当該評価法で、新しい噴霧式抗菌技術を評価したところ、明らかな抗菌性と抗ウイルス性が確認できた。また、一般に流通する国際標準が認める抗菌剤との比較試験においても高い優位性が示された(上図)。
ポイントと今後の展開
国際標準はある一定の技術レベルを求めるもの。それ以上の技術レベルを達成することで、国際標準を超える技術開発が可能であり、ブランド化につながると考えている。国際標準とは守るべきものではなく、超えることで新たな技術開発につながる。開発した評価法のJIS化を視野に入れている。
用語解説
抗菌性:殺菌力があり、噴霧された箇所において微生物の生育を抑える性質。エタノールには殺菌力があるが、噴霧された箇所で維持されないので抗菌性はない
JIS:日本の産業製品に関する規格や測定法などが定められた日本の国家規格のこと
- カテゴリー
- news
- コンバーティングニュース

